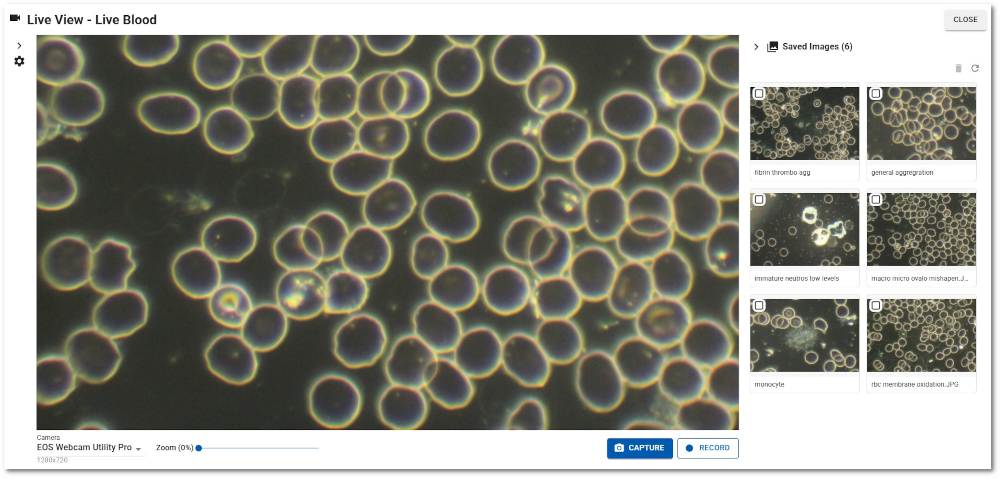
live blood image

Revolutionise your Live & Dry Blood Analysis workflow
Introducing AnalystAssist, the powerful Live Blood Analysis software platform

AnalystAssist is professional practice management software, built exclusively for Live & Dry Blood Analysts.
Designed by practitioners, for practitioners; used by naturopaths, nutritional therapists, medical staff and complementary health practitioners.
Start a FREE trial today
*Desktop browser required
AnalystAssist is fully secure and designed to save you time:
View & capture blood images from your microscope, directly in the app
Obtain New Client/Patient onboarding information & consent digitally
Store all Client/Patient data and images securely and legally
Generate & send bespoke Client/Patient reports effortlessly
Create Form and Report templates easily with a drag & drop WYSIWYG visual editor
Monitor treatment progress, by comparing previous Appointment results
AnalystAssist uses AI trained in Live & Dry Blood Analysis* to support your analysis process:
AI TUTOR - The Agent reviews all Appointment and Client data and suggests possible investigation/treatment pathways.
VOICE DICTATION - AI language model punctuates auto-transcribed speech in real time and offers voice-controlled formatting, making report writing much quicker and easier.
AI IDENTIFY - [COMING SOON] - Image pattern analysis supports the User with identifying blood constituents.
*Trained using Naturecure Academy’s Live & Dry Blood Analysis Training course material.
Click here to learn more about AnalystAssist Pricing & Features
AnalystAssist - First Look & Workflow Demonstration
For feature spotlights, update announcements, and a chance to connect with other AnalystAssist users.

Why do we need dedicated Live Blood Analysis software?
Before AnalystAssist, practitioners relied on paper records, generic health practice software, non-specific microscope camera software and time-consuming manual reporting — none of which were designed for the unique workflow of a Live Blood Analysis (LBA) session.
Generating professional-looking reports for Clients could take hours, filling in the relevant information in each section, and copying & pasting blocks back and forth depending on each Client’s specific needs.
Client data including blood images, health questionnaires, and treatment plans were stored in various places on a practitioner’s computer, difficult to access and possibly not in a legally data-compliant way!
AnalystAssist replaces all of that with a single, secure, cloud-based platform: from sending digital consent forms before the appointment, to connecting your darkfield/phase contrast microscope camera, capturing and comparing blood images across sessions, scoring blood indications, and generating beautifully branded client reports with AI-assisted dictation - AnalystAssist does it all and holds all Client data in one easily-accessed place, whilst being fully data-compliant.
AnalystAssist is not medical software, laboratory software, or a diagnostic tool. It is the professional practice management solution that the global community of live blood analysis practitioners has been calling out for!

Bespoke software for you
Live Blood Analysis software designed specifically by and for Live & Dry Blood analysts.
Manage all Client/Patient and Appointment records, including appointment notes, blood images, indication scorecards and reports.
Conducting appointments and reporting to Clients/Patients made simple.
Feature rich
Connects directly to your microscope camera - store blood images and easily compare with previous appointments.
Email Clients/Patients directly from the app.
Send digital forms - automatically stored in their Client Record on submission.
AI-powered dictation feature for easy report writing - dictate live or upload sound files.
Build your own bespoke branded Form and Report templates.

Data Security & Compliance
Stores Client/Patient data securely in the Microsoft cloud.
Fully encrypted while stored and in transit.
Data backed up regularly, and isolated to user.
Data storage and processing done locally on regional servers*.
Fully HIPAA, GDPR, PIPEDA, AuPA compliant for Personal Health Information.
Remove all your data at any time.
*For users in UK, USA, Canada & Australia.
Start a FREE trial today
*Desktop browser required

Interested in Live Blood Analysis Training?
New to Live & Dry Blood Analysis or looking to refresh your skills?
Join students from over 30 countries worldwide, undertaking professional Live & Dry Blood Analysis Training with Naturecure Academy. The world’s foremost online Blood Analysis training organisation.
Turnkey Live & Dry Blood Analysis
Microscopy Package
Includes: Brunel Haemascope 100W Darkfield microscope, 4K USB Camera, Slides, Coverslips, Immersion Oil, Dust cover & FREE worldwide shipping
What are Live Blood Analysis and Dry Blood Analysis?
Live Blood Analysis (also known as Live Blood Microscopy or Live Blood Cell Analysis) is a holistic health assessment technique used by naturopaths, nutritional therapists, and complementary health practitioners worldwide. Using a darkfield/phase contrast microscope, a practitioner observes a fresh drop of blood in real time to assess the condition of blood cells and plasma — gaining insights into nutritional status, oxidative stress, and the body's internal terrain.
Dry Blood Analysis (the Oxidative Stress Test) is a complementary process that examines dried blood patterns for further indications of imbalance.
Neither technique is a medical diagnostic procedure. Click here to learn more about Live & Dry Blood Analysis.


About AnalystAssist
AnalystAssist is developed by Naturecure Academy Ltd, the UK's leading online Live Blood Analysis training organisation.
Naturecure Academy have trained students from more than 30 countries worldwide, aiming to to become certified Live Blood Analysts through our professional courses.
Through that training work, and in our own clinics, our team have experienced firsthand the frustration that every practitioner faces: there was no dedicated software for managing a live blood analysis practice. Appointments were documented across multiple disconnected tools — microscope images saved to desktop folders, notes typed into Word documents, reports built from scratch in a design tool, and client records kept in a spreadsheet. None of it was designed for the specific workflow of a blood analysis session.
AnalystAssist was built to solve that problem. Every feature in the platform — from the darkfield/phase contrast microscope camera integration to the blood indication scoring system to the AI-assisted dictation for report writing — was designed around the actual experience of performing live and dry blood analysis appointments with real clients.
After 8 months of design, development and testing, the result is AnalystAssist, the software platform built specifically for Live Blood Analysts and Dry Blood Analysts: a secure, compliant, cloud-based system that handles every step of the practitioner workflow.

AnalystAssist is developed and maintained by Naturecure Academy Ltd, registered in England and Wales (Company No. 11007573).
For training in Live and Dry Blood Analysis, visit: livebloodanalysistraining.com
For sales and access enquiries: sales@analystassist.com




